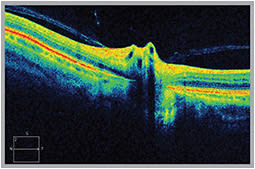

CLINICAL
the back
Are you Retina Ready?
Prepare your practice by employing the necessary technology.
SHERROL A. REYNOLDS O.D., F.A.A.O., AND JOSEPH PIZZIMENTI O.D., F.A.A.O., FT. LAUDERDALE, FLA.
Retinal disease is on the rise. For example, an estimated 13 million people are currently afflicted with AMD, and we can expect to see more patients with AMD in our practices as the population ages.
With the ever-increasing volume of patients with retinal disease, it is critical for clinicians to be equipped to properly diagnose and educate — and retain — these patients.
Here, we discuss the technologies clinicians can employ to improve their ability to detect and manage retinal disease.
1 Condensing lenses
An array of new condensing lenses allow for either a larger field of view, fantastic views of the posterior pole or more magnification.
The slit lamp and binocular indirect ophthalmoscope provide excellent retinal views when a condensing lens is introduced. However, some clinical signs can still be overlooked. A good tip is to use the red-free filter to help assess changes in specific retina layers and determine lesion depth. A deeper lesion (i.e., choroidal nevus) may disappear when using red-free.
The slit beam, or Watzke-Allen, test provides a subjective assessment of visual function in testing for a full-thickness retinal defect. For suspected macular holes that are equivocal or do not lend themselves to observation, consider performing this technique. The test is performed at the slit lamp using a fundus lens and placing a narrow vertical slit beam through the fovea. A positive result is obtained when patients with full-thickness macular defects detect a central break in the vertical light beam. Or, the target can be presented using a Maddox rod or a direct ophthalmoscope.
OCT reveals an anomalous posterior vitreous detachment (PVD) leading to vitreopapillary traction syndrome (VPTS).
A three-mirror lens provides a detailed view of retinal architecture. Each mirror is tilted at a different angle to give a magnified view of mid-peripheral or peripheral pathologies. Consider using this technique with suspicious choroidal lesions (i.e., nevus or melanoma) or retinal breaks. The central lens enables the assessment of the posterior pole, especially in cases of subtle maculopathies, such as cystoid macular edema (CME), optic nerve disorders or elevation, or when fine stereoscopic detail is critical.
Peripheral retinal lesions may be difficult to identify and evaluate. Scleral indentation (depression) enables the view of the peripheral retina in profile. It can be performed using any number of metal depressors or a cotton tip applicator. This technique is part of a detailed evaluation of the anterior retina and peripheral vitreoretinal interface, especially when looking for small retinal breaks, cystic tufts or traction. This method can also assess the elevation of retinal lesions.
2 Digital fundus camera
Fundus photography not only aids in diagnosis, it captures retinal pathologies, such as early DR, that may be missed by the naked eye. It is beneficial in documenting, managing, but most importantly, educating the patient on his or her condition(s).
Some of the new cameras can adapt to your smartphone. Others are available in combination with an OCT system, thus providing cross-sectional views of retinal layers. Widefield retinal imaging offers panoramic fundus assessment in one capture.
3 OCT/SD-OCT
OCT has improved our ability to understand, diagnose, monitor and incorporate therapy for a wide range of vitreoretinal conditions. OCT provides information about structural changes, and it enables early diagnosis of subtle vitreomacular traction or vitreopapillary traction.
In addition, OCT has allowed us to better assess early macular damage in patients on hydroxychloroquine (Plaquenil, Sanofi Aventis) or chloroquine (Aralen, Sanofi Aventis) therapy. OCT is valuable in optic nerve disorders, such as glaucoma, by providing retinal nerve fiber layer analysis as well as ganglion cell complex analysis.
SD-OCT can help assess neurological disease (axonal deficits) like multiple sclerosis, where retinal nerve fiber layer and macular thickness loss occurs. SD-OCT, when paired with tests of visual function such as visual field testing, can provide a structural-functional paradigm of brain injury.
Future generations of OCTs will have increased sensitivity and specificity for early disease detection. Swept-source laser (SS-OCT) will soon provide a greater range of imaging depth and better penetration through opacities. The Doppler OCT can measure blood flow velocity through retinal vessels, which may prove useful in retinal vascular diseases, such as DR.
Back to Basics
Certain regions of the retina can be difficult to visualize, especially when dealing with media opacity or a challenging patient. We, as O.D.s, can sharpen our retinal evaluation by going back to some basic skills that allow for more detailed views. Some of us may not have used these techniques in a while, so now is a good time to fine-tune and practice them.
For example, we often take a quick glance at the vitreous, but numerous studies show that abnormal separation of the vitreous from the retina plays a key role in the pathogenesis of many vitreoretinal disorders. A clinical pearl: Have the patient look up and down while in the slit lamp so you can better visualize red blood cells, inflammatory cells or pigmented cells (“tobacco dust” or “Shafer’s sign”) from a retinal tear or detachment. This should be done meticulously in patients with complaints of flashes and/or floaters, as well as in our growing elderly population. Note a complete posterior vitreous detachment, indicated by the presence of a Weiss ring, or if there is a partial (incomplete) separation.
4 Fundus autofluorescence (FAF)
Fundus autofluorescence (FAF) detects and tracks changes in the retinal pigment epithelium (RPE) lipofuscin, a metabolic biomarker of disease or aging. FAF has played a significant role in analyzing the progression of AMD in that it reveals accumulation of lipofuscin molecules in the retinal pigment epithelium (RPE). The benefits of FAF have been demonstrated with hereditary retinal disorders, toxic maculopathy (Plaquenil screening), choroidal melanoma and other retinal disease processes. More and more manufacturers are producing retinal cameras and OCTs that include FAF.
5 MPOD-measuring devices
Macular pigment optical density (MPOD) enables clinicians to identify at-risk patients, as well as gauge the effects of dietary changes and supplementation. Results from the recently published AREDS 2 confirmed the benefits of lutein and zeaxanthin in AMD patients. Increased MPOD is associated with improved contrast sensitivity, glare tolerance and improved night-driving ability.
6 Multispectral imaging
Multispectral imaging (MSI) allows visualization of the retina in spectral slices, from the inner limiting membrane to the choroid. MSI can assist in the diagnosis of DR, CME, AMD and conditions that masquerade as AMD, such as polypoidal choroidal vasculopathy. It is available with FAF capability.
7 Ultrasound imaging and Electrophysiology
Both ultrasound imaging and electrophysiology (electroretinogram-ERG) techniques have become progressively more sophisticated. New generation ocular ultrasound offers high-resolution diagnostic imaging that allows for a rapid assessment of retinal pathology. Multifocal electroretinography (mfERG) provides a detailed assessment of the health of the central retina. mfERG offers a precise mapping of dysfunctional areas of the retina.
Being equipped
Optometry is on the forefront of retinal disease. By being retina ready, we can better educate and manage our patients. Clinicians can prepare for tomorrow’s patients today by being properly equipped to provide optimum care. OM
Return on Investment
For some practitioners, the initial cost associated with obtaining new devices (such as an OCT or digital fundus camera) may be viewed as a barrier. However, those who “take the plunge” and appropriately use new technology can realize a sound return on their investment by retaining current patients who develop retinal disease and gaining new ones through expanded treatment offerings.

| Dr. Reynolds is an associate professor at the Nova Southeastern University College of Optometry. She is the clinical preceptor/attending in the college’s diabetes and macular clinic and a fellow in the Optometric Retinal Society. She serves as the chairperson for the Florida Optometric Association Healthy Eyes Healthy People Committee. E-mail her at sreynold@nova.edu. |

| Dr. Pizzimenti is an associate professor at Nova Southeastern University College of Optometry. He is also a frequent speaker and writer on age-related eye disease. E-mail him at pizzimen@nova.edu, or send comments to optometricmanagement@gmail.com. |



